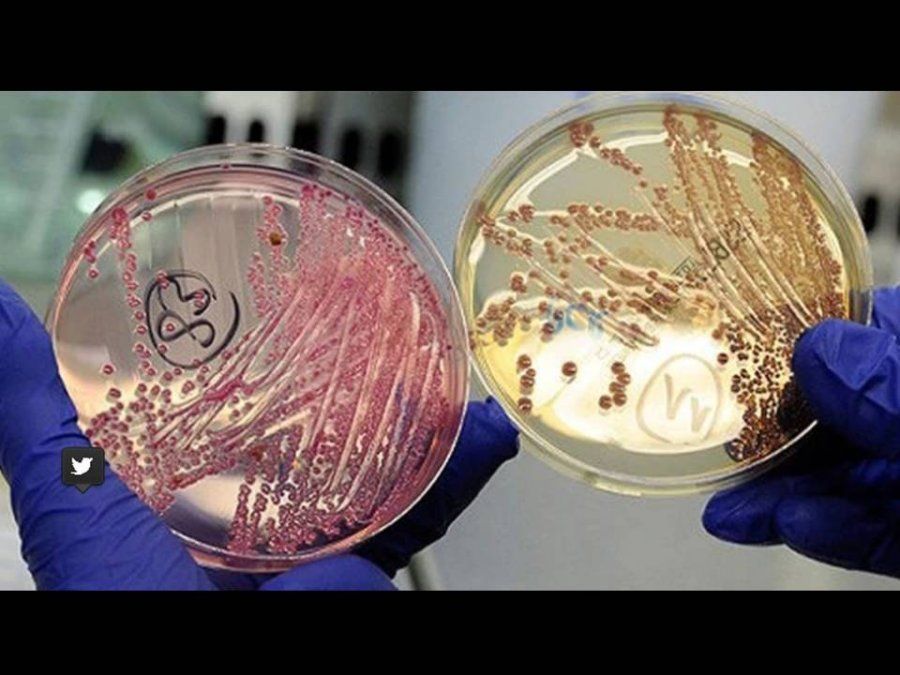

La alianza entre la ANLIS-Malbrán y el Centro para el Control y la Prevención de Enfermedades (CDC) estadounidense permitirá arribar a diagnósticos certeros y tratamientos más eficaces para tratar patógenos que amenazan la salud pública.
Una gran base de datos de los agentes patógenos más peligrosos del mundo, como bacterias, virus y hongos, entre otros, compartirán a partir de ahora Argentina y Estados Unidos, gracias a un acuerdo en conjunto de gobierno y de las agencias de salud nacionales de ambos países.
Ayer, autoridades sanitarias del Centro para el Control y la Prevención de Enfermedades (CDC) que pertenece al Departamento de Salud y Servicios Humanos de los Estados Unidos y la Administración Nacional de Laboratorios e Institutos de Salud ANLIS-Malbrán estamparon la firma en la residencia del Embajador de Estados Unidos en Argentina, Edward Prado, lo que permite acceder a una gran plataforma compartida de agentes infecciosos, lo que constituye un avance crítico y de extrema relevancia para la Salud Pública global.

Los centros de salud trabajarán en forma conjunta para la identificación de nuevas amenazas sanitarias (Shutterstock)
En este sentido, el trabajo conjunto entre las dos entidades permitirá ampliar la capacidad de la red MicrobeNet –una biblioteca en línea de casi 2.400 bacterias y hongos raros y emergentes que proporciona acceso en tiempo real para identificar infecciones raras–, e incluir datos consultables obtenidos mediante la técnica MALDI-TOF provenientes del ANLIS.
ANLIS desde 2015 tiene una gran base de datos y una red de espectrometría de masa. Esta red concretamente son personas que trabajan en la identificación de patógenos y agentes infecciosos.
Cuando la gente del CDC conoció esta red y su base de datos, que incluye por ejemplo la morfología o de la secuencia genética de varios agentes patógenos que ellos no tenían, les pareció interesante unir sus datos con los de Argentina y ofrecerla a la comunidad científica internacional para detectar mejor las amenazas infecciosas, como bacterias, virus u hongos y contribuir así a un mejor diagnóstico y más rápido y eficaz tratamiento.
La firma del convenio en la residencia del embajador de EEUU en Argentina. De izquierda a derecha: la doctora Claudia Perandones, el embajador Edward Prado, el secretario de Salud, Adolfo Rubinstein y el doctor John McQuiston (Foto Embajada de EEUU)
La firma del convenio en la residencia del embajador de EEUU en Argentina. De izquierda a derecha: la doctora Claudia Perandones, el embajador Edward Prado, el secretario de Salud, Adolfo Rubinstein y el doctor John McQuiston (Foto Embajada de EEUU)
La base en conjunto se estrenó esta semana y ya tuvo 28.000 consultas de laboratorios de microbiología y agencias sanitarias de todo el mundo para corroborar o certificar diagnósticos en forma precisa. Además, la ANLIS ya recibió la comunicación de varios países de Latinoamérica que se quieren sumar y recibir consultas.
Fuente: Infobae